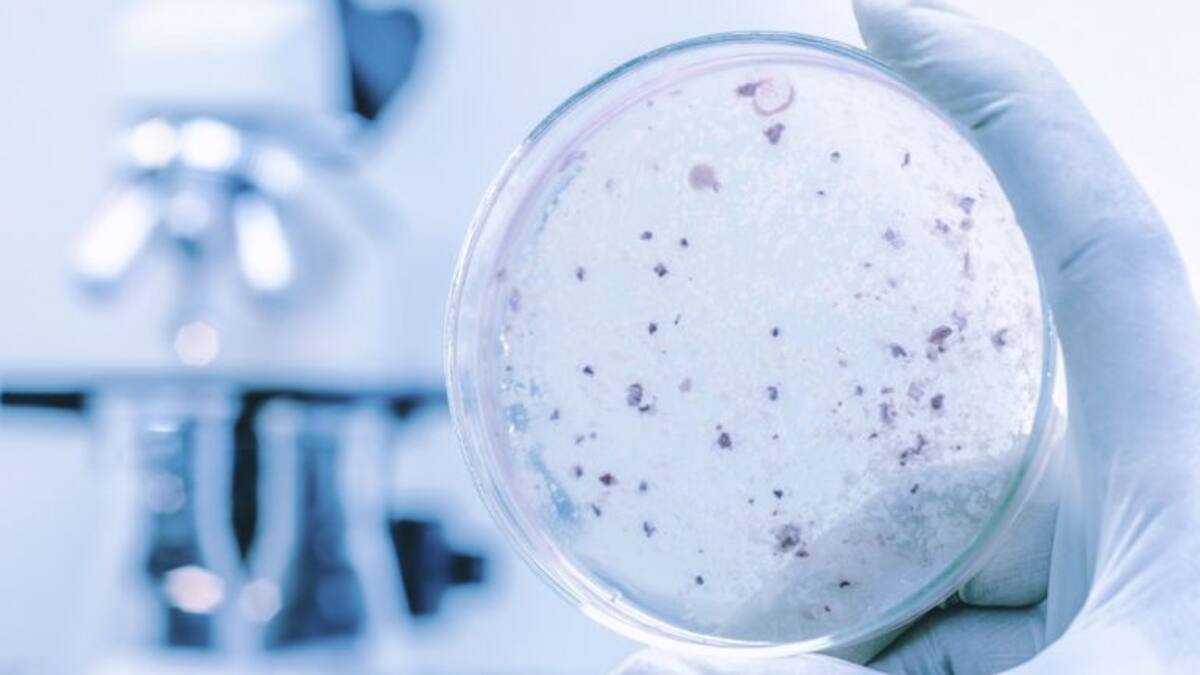
Las mujeres científicas, Medalla de las Cortes de Aragón 2018

Pepe Lasmarías
19/04/2018
17/04/2018

Lo peor de la riada ya ha pasado y deja 14.200 hectáreas inundadas
Los datos "son optimistas" y se ha decidido rebajar el nivel de emergencia de 2 a 1. Poco a poco se retirará la Unidad Militar de Emergencias
17/04/2018 - 14:17
Mónica Farré | Esther Orera | Pepe Lasmarías
Zaragoza
11/04/2018

Sijena se podrá visitar de martes a domingo desde mediados de 2020
Gobierno de Aragón y arquitectos han presentado el Plan Director para el monasterio, Ampliará la zona expositiva, que será compatible con la vida monástica
11/04/2018 - 14:35
Pepe Lasmarías
Zaragoza
09/04/2018

Las Cortes abren sus puertas a todos los aragoneses el Día de Aragón
Lo podrán hacer llamando desde este martes, día 10 de abril, y hasta el próximo lunes, día 16, para reservar plaza, a los teléfonos de las Cortes 976 28 95 02 y 976 28 95 03
09/04/2018 - 14:43
Pepe Lasmarías
Zaragoza
06/04/2018

35 medidas para generar empleo joven y mejorar la formación continua
El Gobierno de Aragón impulsa un Plan de Empleo Joven destinado a jóvenes entre 16 y 35 años, con una inversión de 90 millones de euros hasta 2020. Contempla ayudas a la Seguridad Social y cursos personalizados
06/04/2018 - 14:50
Pepe Lasmarías
Zaragoza
05/04/2018

Se pone en marcha una comisión para evaluar los cambios en Sucesiones
Estará presidida por Violeta Barba y las sesiones serán públicas pero sin público. En la primera reunión, el 11 de abril, decidirán quiénes serán los comparecientes y expertos. No tiene fecha de finalización
05/04/2018 - 13:11
Pepe Lasmarías
Zaragoza
04/04/2018

La ley LGTBI reconoce la diversidad e incluye sanciones de hasta 45.000 euros
Abordará campañas y planes de prevención de enfermedades de transmisión sexual y un protocolo de la Policía ante delitos de odio
04/04/2018 - 12:47
Pepe Lasmarías
Zaragoza
03/04/2018

"Sucesiones solo lo pagan los que más tienen"
Solo un 9% de parientes más cercanos están obligados a pagar por heredar, como reconoce el consejero de Hacienda, Fernando Gimeno. Los herederos de los grupos 1 y 2, los familiares directos, no pagan si heredan por debajo de los 150.000 euros
03/04/2018 - 14:13
Pepe Lasmarías
Zaragoza
01/04/2018

¿Cómo ayudar al pequeño comercio aragonés?
Las ayudas al pequeño comercio provocan diferencias entre PSOE y Podemos
01/04/2018 - 13:38
Pepe Lasmarías
Zaragoza
26/03/2018

Si se suprime Sucesiones habrá que buscar otros ingresos
Lo dice la interventora del Gobierno de Aragón, que no ha querido entrar en la polémica pero sí que plantea que si se suprime o bonifica más este impuesto habrá que plantear alternativas para compensar las pérdidas
26/03/2018 - 14:44
Pepe Lasmarías
Zaragoza
25/03/2018
24/03/2018

Desconvocados los paros parciales en Aramón
Los trabajadores de las estaciones de esquí del Grupo Aramón llegaban anoche a un acuerdo con la empresa, tras estar reunido durante todo el día con la empresa en el SAMA, el Servicio de Mediación y Arbitraje. Se desconvocan los paros previstos para los días 30 y 31 de marzo
24/03/2018 - 07:57
Pepe Lasmarías
Zaragoza
22/03/2018

Antes de un trasvase, "hay un larguísimo recorrido para mejorar la gestión en el día a día"
Miguel García Lapresta, vicepresidente de Zinnae, el clúster de empresas dedicadas a la gestión del agua, remarca que está pendiente un pacto nacional del agua despolitazado. Y recuerda que el agua es "un bien común"
22/03/2018 - 12:38
Pepe Lasmarías | Óscar Aribau
Zaragoza
21/03/2018

Un plan ambicioso que hizo aguas
Es la principal conclusión que se extrae tras escuchar a los primeros comparecientes en la comisión de investigación de las Cortes para analizar el Plan de Depuración El Gobierno de Aragón tomó decisiones políticas para acelerar la construcción de las depuradoras, pero sin éxito El Ministerio de Medio Ambiente guardó silencio mientras veía como el ejecutivo aragonés, al llegar la crisis, no podía hacer frente al convenio que habían firmado
21/03/2018 - 16:57
Pepe Lasmarías
Zaragoza
19/03/2018

¿Falda sí, falda no?
Podemos plantea que no se obligue a llevar falda a las niñas en aquellos colegios donde el alumnado lleva uniforme y que tengan la opción del pantalón. Defienden que la falda no da la suficiente libertad para bajar por un tobogán o jugar al fútbol
19/03/2018 - 21:24
Pepe Lasmarías
Zaragoza
15/03/2018

Doble propuesta de Lambán a Zaragoza para la gestión del ICA
El presidente de Aragón ha propuesto este jueves en las Cortes dos soluciones para el Impuesto de Contaminación de las Aguas: que la DGA gestione directamente la depuración de las aguas de la capital aragonesa o que el Ayuntamiento se encargue de cobrar el ICA
15/03/2018 - 13:26
Pepe Lasmarías
Zaragoza